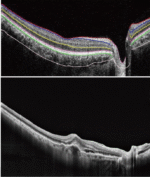

New generation fully automated artificial Intelligence OCT Ophthalmic Optical coherence Tomography
A new generation of fully automatic artificial intelligence OCT
OCT-1000 New generation fully automated artificialintelligence OCT
A fullyautomatic artificial intelligence OCT with fully independent intellectu-al property rights. Combined with multi-image registration and imageenhancement technology and industry-leading analysis technology, itprovides a full-stack solution for clinical diagnosis and treatment,including automatic image capture, accurate image analysis, intelli-gent eye health record management, and real-time data sharing onthe cloud.
Fully automatic operation
High-resolution imaging
Fast pupil positioning and focusing; Fullvoice guidance; It takes an average of 2minutes to complete the examination ofboth eyes of one patient.
12mm X 9mm Large field scan; It coversboth the macular area and the optic discarea. Retinal disorders can be compre-hensively detected
AI Image Analysis
Industry-leadingimage algorithms
It can be used for auxiliary diagnosis of16 main fundus lesions. The lesion areawas accurately identified, segmentedand automatically marked.
Provide reliable and accurate quantitativeanalysis(such as mean choroidal thick-ness, central macular thickness, etc.)
Intelligent eye healthmanagement
Perfect adaptationto all kinds of scenarios
Automatically establish eye healthrecords for users; Mobile scanning codecan quickly receive the inspection report.
Using cloud architecture; Real-time shar-ing of examination image data; Toprovide platform support for remotehierarchical medical alliance
Technical Parameter:
| Measuring characteristics | Axial resolution (in the tissue) : 5um |
| Horizontal resolution (in the tissue): 20um | |
| Scanning characteristics | The highest scanning speed : >20000/50000/80000 times/second |
| Scan depth: 2.3mm | |
| Scan depth: 2.3mm | |
| Light source characteristics | Centre wavelength: 840nm |
| Optical power: ≤750uW | |
| Refractive compensation range: -20D ~ + 25D |
Scanning Modes
| Mode | Scanning ways | Physical size | Slice Direction |
| Large field | Single-line | 12mm | Horizontal |
| Six radial lines | 9mm | Per 30° | |
| Large field | 12mm x 9mm | Horizontal or vertical | |
| Glaucoma | Macular area | 6mm x6mm | Horizontal |
| optic disc area | 6mm x 6mm | Horizontal | |
| Anterior segment | Single line | 6mm | Horizontal |
| Six radial lines | 6mm | Per 30° |
Packing List:
| Product Name | Packaging equipment | Packaged weight(kg) | Packaging dimensions: length(cm) | Packaging dimensions: Width(cm) | Packaging dimensions: Height(cm) | Packaging dimensions: Volume(m³) |
| optical coherence tomography OCT-1000 |
OCT Host | 61 | 86 | 69 | 96 | 0.57 |
| Electric Table | 65 | 115 | 70 | 42 | 0.34 | |
| Computer and monitor | 24 | 60 | 60 | 60 | 0.22 | |
| Present | Printer | 9.75 | 51 | 27 | 48 | 0.07 |